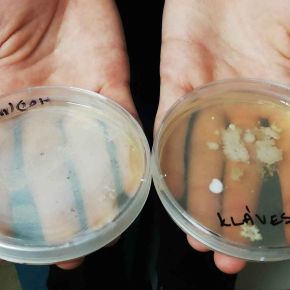

Den otevřených dveří na Povodí Vltavy 24. 3. 2023
10. 9. 2024
Dne 24. 3. 2023 se vybraní žáci 8. ročníků zúčastnili Dne otevřených dveří na Povodí Vltavy. Seznámili se s průtokovou analýzou, se zajišťováním tvrdosti povrchové vody, s úsekem vzorkování, s laboratoří mikrobiologie a hydrobiologie a mohli si vyzkoušet nějaké pokusy v laboratoři organické analýzy... Na Povodí Vltavy pracují odborníci a zároveň moc milí lidé. Jako památku si žáci vybrali dáreček. Všem se akce moc líbila.